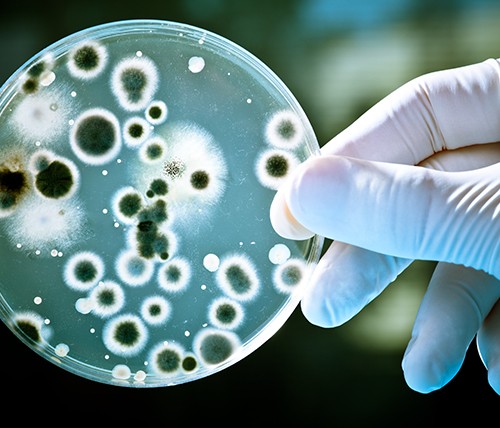
coltura batterica

Pronto soccorso per il settore alimentare: tutto quello che bisogna sapere per essere a norma
Il Decreto Legislativo 81 del 2008 è la norma di riferimento più recente per quanto riguarda la salute e la sicurezza nei luoghi di lavoro. Ha rinnovato, riunito e armonizzato tutte le disposizioni precedenti, abrogandole e sostituendole con un unico testo che recepisce le direttive comunitarie. Vengono fornite indicazioni e requisiti riguardanti i luoghi di lavoro, le attrezzature, i dispositivi di protezione individuale, I kit di pronto soccorso, la segnaletica, gli agenti fisici e biologici, le sostanze pericolose od esplosive, i soggetti responsabili e molto altro.
In particolare, l’articolo 45 definisce gli obblighi del datore di lavoro in materia di primo soccorso, facendo riferimento a quanto stabilito in precedenza dal Decreto Ministeriale 388 del 15 luglio 2003. Questo decreto stabilisce con chiarezza quali sono le attrezzature di primo soccorso obbligatorie per ogni azienda in base al tipo di attività svolta e al numero di dipendenti.
Le aziende vengono suddivise i tre gruppi:
GRUPPO A – comprende tre sottogruppi:
- Le aziende con obbligo di notifica di cui all’art.2 del D.L.vo 334/99 (aziende a rischio di incidenti rilevanti connessi a determinate sostanze pericolose): centrali termoelettriche e laboratori nucleari; aziende estrattive e altre attività minerarie, lavori in sotterraneo e le aziende che fabbricano esplosivi, polveri e munizioni;
- Aziende o unità produttive con oltre 5 lavoratori con indice infortunistico di inabilità permanente superiore a 4. È il caso ad esempio degli impianti di macellazione (indice infortunistico 6,41) che hanno 6 o più dipendenti.
- Aziende appartenenti al settore agricolo che abbiano oltre 5 lavoratori.
GRUPPO B
- Tutte le aziende che non rientrano nel Gruppo A che abbiano almeno 3 dipendenti (quindi comprende anche le aziende con un indice infortunistico superiore a 4 ma che hanno tra 3 e 5 lavoratori. Se i lavoratori fossero ad esempio 6, l’azienda rientrerebbe nel Gruppo A)
GRUPPO C
- Tutte le aziende che non rientrano nel Gruppo A che abbiano meno di 3 dipendenti (quindi 1 o 2).
Cassette di pronto soccorso per gruppi A e B
In base a questa classificazione vengono stabiliti dei requisiti diversi per quanto riguarda le attrezzature di primo soccorso. Le aziende appartenenti ai Gruppi A e B devono dotarsi di una cassetta di primo soccorso composta come segue (Allegato 1 del DM 388/2003):
- Guanti sterili monouso (5 paia).
- Visiera paraschizzi
- Flacone di soluzione cutanea di iodopovidone al 10% di iodio da 1litro (1).
- Flaconi di soluzione fisiologica ( sodio cloruro – 0, 9%) da 500 ml (3).
- Compresse di garza sterile 10 x 10 in buste singole (10).
- Compresse di garza sterile 18 x 40 in buste singole (2).
- Teli sterili monouso (2).
- Pinzette da medicazione sterili monouso (2).
- Confezione di rete elastica di misura media (1).
- Confezione di cotone idrofilo (1).
- Confezioni di cerotti di varie misure pronti all’uso (2).
- Rotoli di cerotto alto cm. 2,5 (2).
- Un paio di forbici.
- Lacci emostatici (3).
- Ghiaccio pronto uso (due confezioni).
- Sacchetti monouso per la raccolta di rifiuti sanitari (2).
- Termometro.
- Apparecchio per la misurazione della pressione arteriosa.
Cassette di pronto soccorso per gruppo C
Le aziende appartenenti al Gruppo C invece devono dotarsi di un pacchetto di medicazione, composto come segue (Allegato 2 del DM 388/2003):
- Guanti sterili monouso (2 paia).
- Flacone di soluzione cutanea di iodopovidone al 10% di iodio da 125 ml (1).
- Flacone di soluzione fisiologica (sodio cloruro 0,9%) da 250 ml (1).
- Compresse di garza sterile 18 x 40 in buste singole (1).
- Compresse di garza sterile 10 x 10 in buste singole (3).
- Pinzette da medicazione sterili monouso (1).
- Confezione di cotone idrofilo (1).
- Confezione di cerotti di varie misure pronti all’uso (1).
- Rotolo di cerotto alto cm 2,5 (1).
- Rotolo di benda orlata alta cm 10 (1).
- Un paio di forbici (1).
- Un laccio emostatico (1).
- Confezione di ghiaccio pronto uso (1).
- Sacchetti monouso per la raccolta di rifiuti sanitari (1).
- Istruzioni sul modo di usare i presidi suddetti e di prestare i primi soccorsi in attesa del servizio di emergenza.
Kit di pronto soccoso nelle aziende del settore alimentare
Nel caso delle aziende del settore alimentare, indipendentemente dal gruppo di appartenenza, è fondamentale garantire oltre alla sicurezza degli operatori, la sicurezza del prodotto lavorato e il rispetto delle norme di igiene e dei protocolli di qualità.
I dispositivi utilizzati per la medicazione dovrebbero essere idonei al contatto con gli alimenti, di colore blu perché siano immediatamente individuabili
Se dovessero cadere accidentalmente nell’alimento sarebbero infatti più facili da individuare. Inoltre dovrebbero anche essere rilevabili al metal detector e ai raggi X. Un dispositivo è rilevabile al metal detector grazie a filamenti di alluminio incorporati. Devono inoltre essere waterproof, cioè resistenti all’acqua, in quanto gli alimenti sono spesso umidi o comunque è spesso presente acqua.
Supponiamo che in caso di lieve infortunio l’operatore venga medicato (ad esempio applicando un cerotto a un dito) e possa poi riprendere la propria attività. In questo caso è necessario garantire che il contatto tra il cerotto e l’alimento non ne intacchi la qualità trasferendo sostanze indesiderate. In caso si staccasse un frammento di cerotto durante le normali operazioni di taglio, questo frammento dovrebbe essere immediatamente individuabile a vista, grazie al colore blu, oppure utilizzando il metal detector o i raggi X, grazie ai frammenti di alluminio incorporati nel cerotto.
Inoltre per prevenire i rischi legati all’utilizzo di forni, piastre e fornelli è indispensabile avere a portata di mano il materiale sanitario per la cura di bruciature e ustioni. È il caso di cerotti specifici e gel antiustione per dare sollievo immediato.
Questi dispositivi non sono inclusi nelle cassette di pronto soccorso convenzionali ma sono fondamentali per il settore alimentare.
Cassette di pronto soccorso, quali scegliere?
I kit di pronto soccorso Tecnafood sono progettati per fornire tutto l’occorrente per gestire le emergenze nel rispetto delle normative sulla sicurezza, del metodo HACCP e dei principali standard di qualità. A seconda delle esigenze è possibile acquistare una cassetta di pronto soccorso a norma di legge e dotata di dispositivi specifici per il settore alimentare, solo l’integrazione per le aziende alimentari o solo le valigette di pronto soccorso a norma.
Cassetta di Pronto Soccorso Food
Fornisce i dispositivi individuati dall’allegato 1 del DM 388/2003 per le aziende dei Gruppi A e B, oltre a una gamma completa di prodotti certificati per il contatto con gli alimenti, di colore blu e rilevabili sia al metal detector che ai raggi X; il tutto contenuto in una valigetta giallo fluo per rendere immediata l’individuazione in caso di necessità e dotata di supporto a muro. Per sostituire i dispositivi utilizzati sono disponibili due kit di reintegro, con o senza rilevatore di pressione.
Valigette di Pronto Soccorso Multimed AB e Mastermed C
Rispondono ai requisiti del DM 81/2008 e del DM 388/2003 e sono pensate per le aziende dei Gruppi A e B (la Multimed AB) e del Gruppo C (la Mastermed C); sono di colore arancione e sono dotate di supporto a muro.
- Per maggiori informazioni sulla valigetta Multimed AB clicca qui
- Per maggiori informazioni sulla valigetta Mastermed C clicca qui
Valigetta di Pronto Soccorso HACCP
Contiene una gamma completa di prodotti certificati per il contatto con gli alimenti, di colore blu e rilevabili sia al metal detector che ai raggi X: cerotti, fasce, nastro adesivo, cappucci elastici e laccio emostatico. È progettata per le aziende che hanno gia soddisfatto i requisiti di legge ma che vogliono integrare i dispositivi specifici per il metodo HACCP e gli standard IFS e BRC.
Kit di primo soccorso HACCP
comprende un assortimento di dispositivi specifici per l’industria alimentare, racchiusi in una custodia morbida di colore rosso. Questo kit piccolo ma completo è adatto a tutte le aziende della ristorazione e ai ristoranti, può essere riposto in un cassetto o all’interno della valigetta di primo soccorso.
Cerotti e nastri adesivi per il contatto con gli alimenti
Oltre alle valigette di primo soccorso che come abbiamo visto sono regolamentate in modo preciso dalla legge, è buona norma per le imprese del settore alimentare, utilizzare dispositivi di protezione personale specifici.
Le caratteristiche con cui sono progettati i Cerotti blu rilevabili facilitano il lavoro degli operatori, garantiscono la sicurezza degli alimenti e diminuiscono i rischi e i costi legati al richiamo di prodotti o a rilavorazioni:
- il colore blu rende i cerotti per il settore alimentare immediatamente individuabili nell’alimento perchè è ampiamente visibile e difficilmente confondibile con i prodotti lavorati
- in caso non fosse possibile individuarli a vista, sarà possibile tracciarli con l’utilizzo del metal detector o dei raggi X. Qualsiasi prodotto alimentare, contaminato dalla banale caduta di un cerotto è rintracciato ed eliminato tempestivamente salvaguardando la qualità e l’igiene del prodotto lavorato.
- sono ipoallergenici, waterproof e resistenti ai grassi per proteggere la pelle anche a contatto con alimenti umidi o unti
- sono idonei al contatto con gli alimenti il che significa che non ci sarà nessuna migrazione di sostanze indesiderate dal cerotto all’alimento in lavorazione, la cui qualità e sicurezza sarà preservata.
Questi cerotti sono adatti a tutte le aziende del settore alimentare, dalle grandi industrie ai ristoranti, macellerie, forni, imprese di catering e gastronomie.
Cerotto di medicazione autoadesivo per il settore alimentare
Blue è un cerotto di medicazione autoadesivo senza colla. E’ ideale per fasciature strette in qualsiasi punto. La sua particolare composizione permette al nastro di incollarsi su se stesso e non sulla pelle, lasciandola pulita. Garantisce inoltre un’elevata tenuta e resistenza. È idoneo al contatto con gli alimenti, di colore blu e resistente all’acqua e ai grassi. (Guarda il prodotto)
Cerotti rilevabili per ustioni Fresh Gel hanno la triplice funzione di arrestare la bruciatura, di proteggere la pelle danneggiata dando sollievo all’operatore e di preservare l’igiene dei cibi trattati. Il gel di cui è dotato fornisce sollievo immediato dalle bruciature, abbassa notevolmente la temperatura della zona interessata donando una sensazione di freschezza e mantiene umida la zona per agevolare il processo di guarigione. È realizzato in polietilene idoneo al contatto con alimenti, in colore blu e rilevabile al metal detector. Resiste all’acqua e ai grassi. (Guarda la gamma di prodotti per ustioni)
Il Gel per ustioni è disponibile anche in comode bustine monouso da 3,5 ml per tutti gli operatori che utilizzano forni, piastre o fornelli. (Guarda il prodotto)